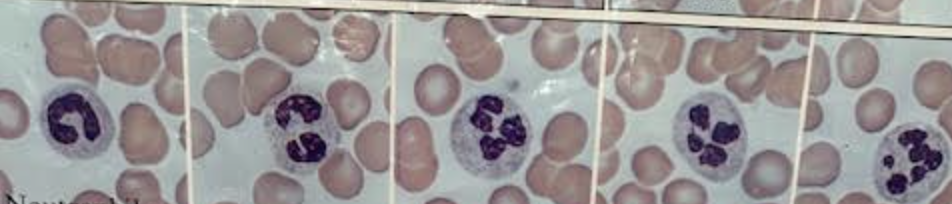
<p>What white blood cell is this</p>
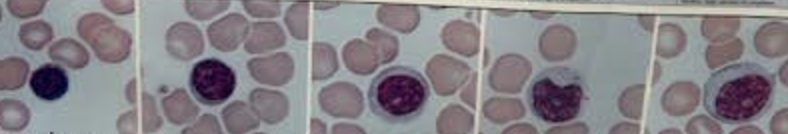
<p>What white blood cell is this</p>

Lab 2: Blood & Circulatory System
0.0(0)
Studied by 0 peopleCard Sorting
1/7
There's no tags or description
Looks like no tags are added yet.
Last updated 11:08 PM on 4/14/26
Name | Mastery | Learn | Test | Matching | Spaced | Call with Kai |
|---|
No analytics yet
Send a link to your students to track their progress
8 Terms
1
New cards
What white blood cell is this
Neutrophils (multi-lobed nucleus)
2
New cards
What white blood cell is this
Lymphocytes (one lobe smooth nucleus)
3
New cards

What white blood cell is this
Monocytes (one lobe granular nucleus)
4
New cards

What white blood cell is this
Eosinophils (two-lobed nucleus)
5
New cards

What white blood cell is this
Basophils (granular)
6
New cards
What is the actual size formula?
number of small divisions observed x size of smallest division (at objective used)
400x = 2.5
100x = 10
40x = 25
7
New cards
What is the drawing magnification formula?
Image Size (in cm) / Actual Size
8
New cards

Hematocrit Diagram
